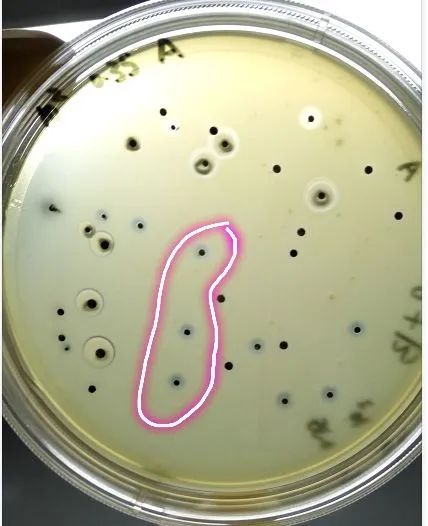
΢��ͼƬ_20241021152219

一、金黄色葡萄球菌在不同培养基上颜色变化的一种归纳性描述:
1. 典型培养基
-
BP琼脂(Baird-Parker Agar):
-

-
菌落颜色:典型的金黄色葡萄球菌在BP琼脂上常呈现灰黑色至黑色,且菌落周围绕以不透明圈(沉淀),其外常有一清晰带(卵磷脂环)。然而,也有时金黄色葡萄球菌不显灰黑色,但其外围仍有一不透明圈。
-
生长特点:菌落圆形、光滑、凸起、湿润,直径约为2-3mm。
-
血平板(Blood Agar):
-

-
菌落颜色:在血平板上,金黄色葡萄球菌菌落常呈金黄色,有时也可能为白色。菌落大而突起,圆形,不透明,表面光滑,周围有溶血圈。
-
生长特点:溶血圈的存在是金黄色葡萄球菌在血平板上的一个显著特征,它反映了该菌产生的溶血素对红细胞的破坏作用。
2. 其他培养基
-
胰酪胨大豆肉汤(Trypticase Soy Broth, TSB):
-
菌落颜色:在液体培养基如TSB中,金黄色葡萄球菌的生长表现为培养基的混浊度增加,菌体呈悬浮状态,无法直接观察到菌落颜色。但通过观察培养基的混浊度可以间接判断其生长情况。
-
-
其他显色培养基:
-
某些显色培养基被设计用于快速检测和鉴定金黄色葡萄球菌。在这些培养基上,金黄色葡萄球菌可能呈现出特定的颜色变化,如黄色晕环等,这些变化有助于快速识别和区分该菌。但具体的颜色变化取决于所使用的培养基种类和配方。
金黄色葡萄球菌在甘露醇高盐琼脂培养基上典型特征

-
金黄色葡萄球菌显黄色,其外围有一黄色的晕环。
关于金黄色葡萄球菌在BP平板上的形态以及后续生化分析
第一种形态:

第二种形态:

第三种形态:

第四种形态:

一些典型可疑平板图如下:

添加微信13371394813申请加入微生物检验技术交流群!

手机版










